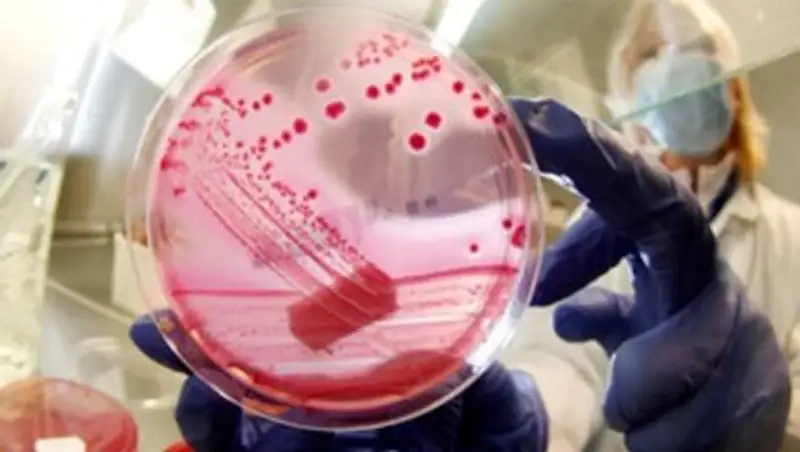
Лагерь в Костанайской области, где отравились дети, могут закрыть до устранения нарушений

В Усть-Каменогорске могут закрыть единственное инфекционное отделение
 Zakon.kz
Zakon.kz
Суд вынес решение приостановить деятельность инфекционного отделения в первой горбольнице – за нарушение санитарных норм.
Пораженные грибком стены, отсутствие вытяжной вентиляции, по мнению служителей Фемиды, создают угрозу здоровью пациентов. Облздрав в срочном порядке выделил миллионы тенге на ремонт больницы и попросил отсрочить выполнение решения, передает корреспондент YK-news.kz.
Напомним, в середине 2013 года в инфекционный корпус первой горбольницы наведалась санэпидслужба. Специалисты обнаружили, что практически все помещения корпуса на момент проверки поразил грибок: и коридоры, и палаты, и буфет, и процедурные кабинеты. Краска на стенах и оконных рамах отслаивалась, штукатурка осыпалась. В боксах не работала вытяжная вентиляция.
Управление госсанэпиднадзора Усть-Каменогорска подало иск в суд с требованием приостановить работу этого отделения до устранения недостатков.
Суд удовлетворил иск. Главного врача больницы оштрафовали на пять МРП, или 8655 тенге.
В этом году, как выяснилось, судебные тяжбы по "инфекционке" продолжились.
Представитель первой горбольницы обратился в суд с просьбой отсрочить приостановление деятельности корпуса, поскольку средства на ремонт уже выделены.
Однако судья специализированного межрайонного экономического суда ВКО 25 февраля этого года вынес определение: отсрочку не давать.
Тем не менее в облздраве настроены весьма оптимистично.
- Мы уже решили эту проблему, - говорит руководитель управления здравоохранения ВКО Вадим Овсянников. - В инфекционном отделении требовался ремонт. Сейчас деньги на эти цели выделены из местного бюджета – около 160 миллионов тенге. В этом году работы будут выполнены. И мы попросили отсрочить действие решения суда, чтобы не пострадали больные. Да, бывают такие ситуации с больницами, поскольку не везде материально-техническая база соответствует требованиям санитарных норм. Мы объясняем, что всё исправим, и санврачи идут на компромисс.
Елена Супрунова
Поделитесь новостью
Читайте также
Если вы видите данное сообщение, значит возникли проблемы с работой системы комментариев. Возможно у вас отключен JavaScript